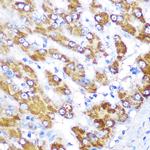
GATM Antibody in Immunohistochemistry (Paraffin) (IHC (P))

Search
Invitrogen
GATM Polyclonal Antibody
{{$productOrderCtrl.translations['antibody.pdp.commerceCard.promotion.promotions']}}
{{$productOrderCtrl.translations['antibody.pdp.commerceCard.promotion.viewpromo']}}
{{$productOrderCtrl.translations['antibody.pdp.commerceCard.promotion.promocode']}}: {{promo.promoCode}} {{promo.promoTitle}} {{promo.promoDescription}}. {{$productOrderCtrl.translations['antibody.pdp.commerceCard.promotion.learnmore']}}

Please note: We are reviewing Western blot images included in the antibody testing data in our catalog, including those provided by third parties. Unless expressly labeled or annotated as “raw-unedited”, Western blot images included in the antibody testing data in our catalog may have been edited, optimized or otherwise adjusted for presentation.
产品信息
PA5-109756
种属反应
宿主/亚型
分类
类型
抗原
偶联物
形式
浓度
规格
纯化类型
保存液
内含物
保存条件
运输条件
RRID
产品详细信息
Immunogen sequence: STQAATASSR NSCAADDKAT EPLPKDCPVS SYNEWDPLEE VIVGRAENAC VPPFTIEVKA NTYEKYWPFY QKQGGHYFPK DHLKKAVAEI EEMCNILKTE GVTVRRPDPI DWSLKYKTPD FESTGLYSAM PRDILIVVGN EIIEAPMAWR SRFFEYRAYR SIIKDYFHRG AKWTTAPKPT MADELYNQDY PIHSVEDRHK LAAQGKFVTT EFEPCFDAAD FIRAGRDIFA QRSQVTNYLG IEWMRRHLAP DYRVHIISFK DPNPMHIDAT FNIIGPGIVL SNPDRPCHQI DLFKKAGWTI ITPPTPIIPD DHPLWMSSKW LSMNVLMLDE KRVMVDANEV PIQKMFEKLG ITTIKVNIRN ANSLGGGFHC WTCDVRRRGT LQSYLD
靶标信息
AGAT, also known as glycine amidinotransferase (L-arginine:glycine amidinotransferase), GATM or transamidinase, is a 423 amino acid protein belonging to the amidinotransferase family. Encoded by a gene that maps to human chromosome 15q21.1, AGAT exists as three alternatively spliced isoforms and consists of a homodimer, with equilibrium between monomeric and dimeric forms favoring a monomer subunit structure. AGAT localizes to mitochondrial inner membranes, peripheral membranes and cytoplasm. Biallelically expressed in placenta and fetal tissues, AGAT is also expressed in brain, heart, liver, lung, salivary gland and skeletal muscle tissue, with high expression in kidney. AGAT is elevated in the myocardium during heart failure and is decreased in inter-uterine growth restriction (IUGR)-associated placenta. AGAT catalyzes biosynthesis of guanidinoacetate, the immediate precursor of creatine, which plays a vital role in energy metabolism in muscle tissues. AGAT defects are associated with arginine:glycine amidinotransferase deficiency, an autosomal recessive disorder characterized by developmental delay or regression, mental retardation, severe disturbance of expressive and cognitive speech and severe depletion of creatine/phosphocreatine in brain. AGAT may be linked to embryonic and central nervous system development and may function in heart failure response by elevating local creatine synthesis.
仅用于科研。不用于诊断过程。未经明确授权不得转售。
生物信息学
蛋白别名: AT; Glycine amidinotransferase, mitochondrial; L-arginine: glycine amidinotransferase; L-arginine:glycine amidinotransferase; Transamidinase
基因别名: 1810003P21Rik; AGAT; AI314789; AT; GATM
UniProt ID: (Mouse) Q9D964, (Rat) P50442
Entrez Gene ID: (Mouse) 67092, (Rat) 81660




